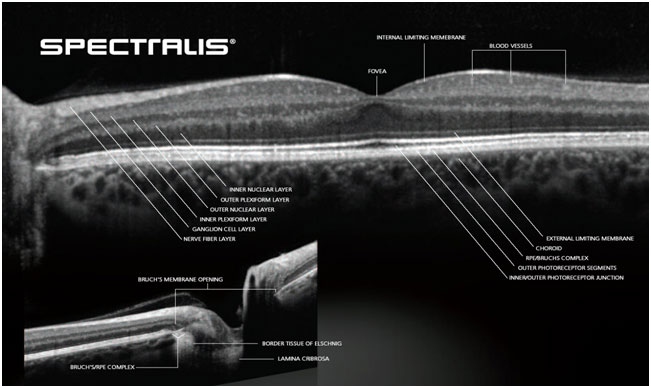

OCT
Heidelberg Spectralis
NOVINKA

Nejkomplexnější diagnostický přístroj pro zobrazování sítnice, zrakového nervu a předního segmentu oka.
Spectralis disponuje unikátními systémy pro zvýšení kvality a konzistence měření jako jsou:
- Aktivní EYE TRACKING v reálném čase- Zajišťuje kompenzaci pohybu očí, pohybových artefaktů ve snímku a automatické optické ukotvení snímku pří následných ( follow up) vyšetřeních
- Technologie redukce šumu
Spectralis HRA
Laserový konfokální angiografický skenovací systém umožňující následující zobrazení:
- Fluoresceinová angiografie (FA)
- Indocyaninová angiografie (ICGA)
- Autofluorescence fundu (BAF)
- Infračervené zobrazení fundu (IR)
- „red free“ zobrazení (RF)
- Multicolor zobrazení ( unikátní technologie snímání fundu 3mi laserovými paprsky)
- Možnost snímky jednotlivých funkcí porovnávat a zobrazovat zároveň
Spectralis OCT
Jedná se o optický koherentní tomograf, který umožňuje vysokorychlostí snímání struktur oka s vysokým rozlišením a vysokým prostorovým kontrastem.
- OCT řezy s libovolně nastavitelnou orientací a hustotou
- OCT angiograii
- Infračervené reflexní zobrazení
- Multicolor zobrazení
- Autofluorescenční zobrazení fundu (BAF)
- Vzájemné kombinace jednotlivých modalit
Spectralis HRA+OCT
Kombinuje zobrazovací modality přístrojů Spectralis HRA a Spectralis OCT do jednoho zažízení
Profesionální servis
Náš tým vyškolených servisních techniků zajišťuje technické poradenství, instalaci přístrojů u zákazníka po koupi i při ukázkovém provozu, záruční i pozáruční servis, rezpečnostně technické kontroly dle platné legislativy, zaškolení obsluhujícího personálu...